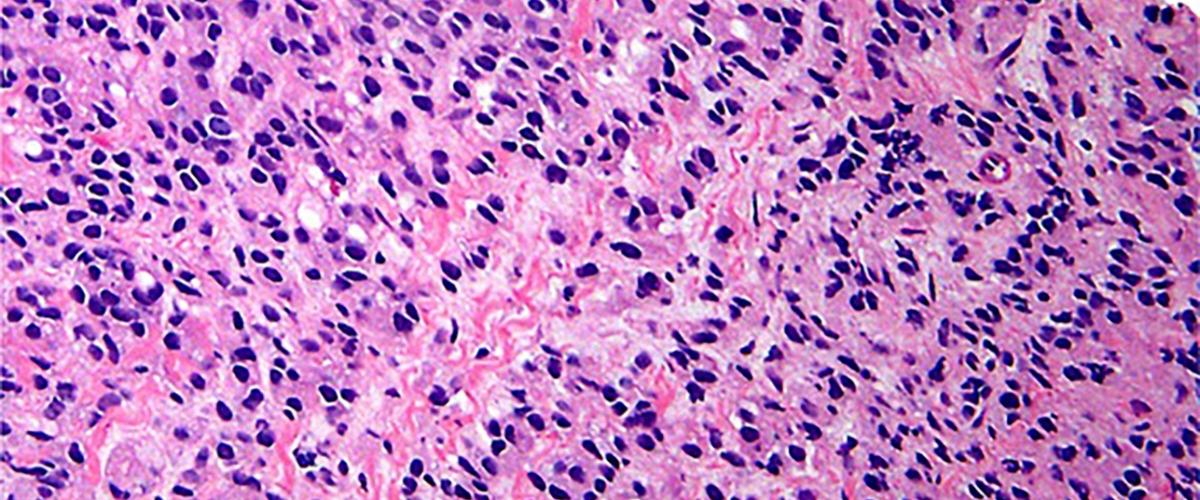
TODO:

Рак предстательной железы считается одним из наиболее распространенных видов рака у мужчин. Хотя большинство случаев развиваются очень медленно и не требуют интенсивного лечения, иногда опухоль ведет себя очень агрессивно и дает метастазы. Задача врачей — выявить агрессивные формы рака простаты на ранней стадии. К сожалению, сделать это непросто.
Специалисты из Университета Восточной Англии, о работе которых рассказывает New Atlas, решили выяснить, как активность генов сказывается на агрессивности рака простаты. Для этого они тщательно изучили 2000 образцов опухолей.
Оказалось, что для некоторых опухолевых клеток характерен своеобразный рисунок активности генов. Исследователи назвали этот подтип клеток DESNT. Анализ показал, что чем больше в опухоли таких клеток, тем выше скорость развития рака простаты. Авторы надеются, что DESNT станет надежным биомаркером, с помощью которого можно будет определять случаи, требующие быстрого инвазивного лечения.
Другой подход к борьбе с раком простаты представили австралийские исследователи из Центра Питера Маккалума. Они разработали новый метод визуализации, позволяющий выявлять случаи рецидива опухоли после операции или лучевой терапии.
Новая методика представляет собой комбинацию компьютерной томографии и позитронно-эмиссионной томографии. Пациенту вводят молекулу PSMA, которая специфически прикрепляется к злокачественным клеткам, а затем проводят сканирование. В результате врачи могут увидеть как изменения в структуре тела, так и циркулирующие в крови раковые клетки.
Эксперименты показали, что комбинированная методика выявляет метастазы рака простаты в 92% случаев. Для сравнения, точность традиционного подхода составляет всего 65%.
К сожалению, новый подход более дорог, чем традиционные. В настоящее время исследователи пытаются оценить экономический эффект от его повсеместного внедрения. Возможно, им удастся доказать, что точный прогноз развития рака простаты снижает долгосрочные расходы на здравоохранение.
Американские исследователи обнаружили, что десяткам различных видов рака соответствуют уникальные «подписи» циркулирующей в крови бактериальной ДНК. Это может стать основой для простого диагностического теста по выявлению заболевания на самых ранних стадиях. Но для начала необходимо понять, что именно связывает бактерии с опухолями.